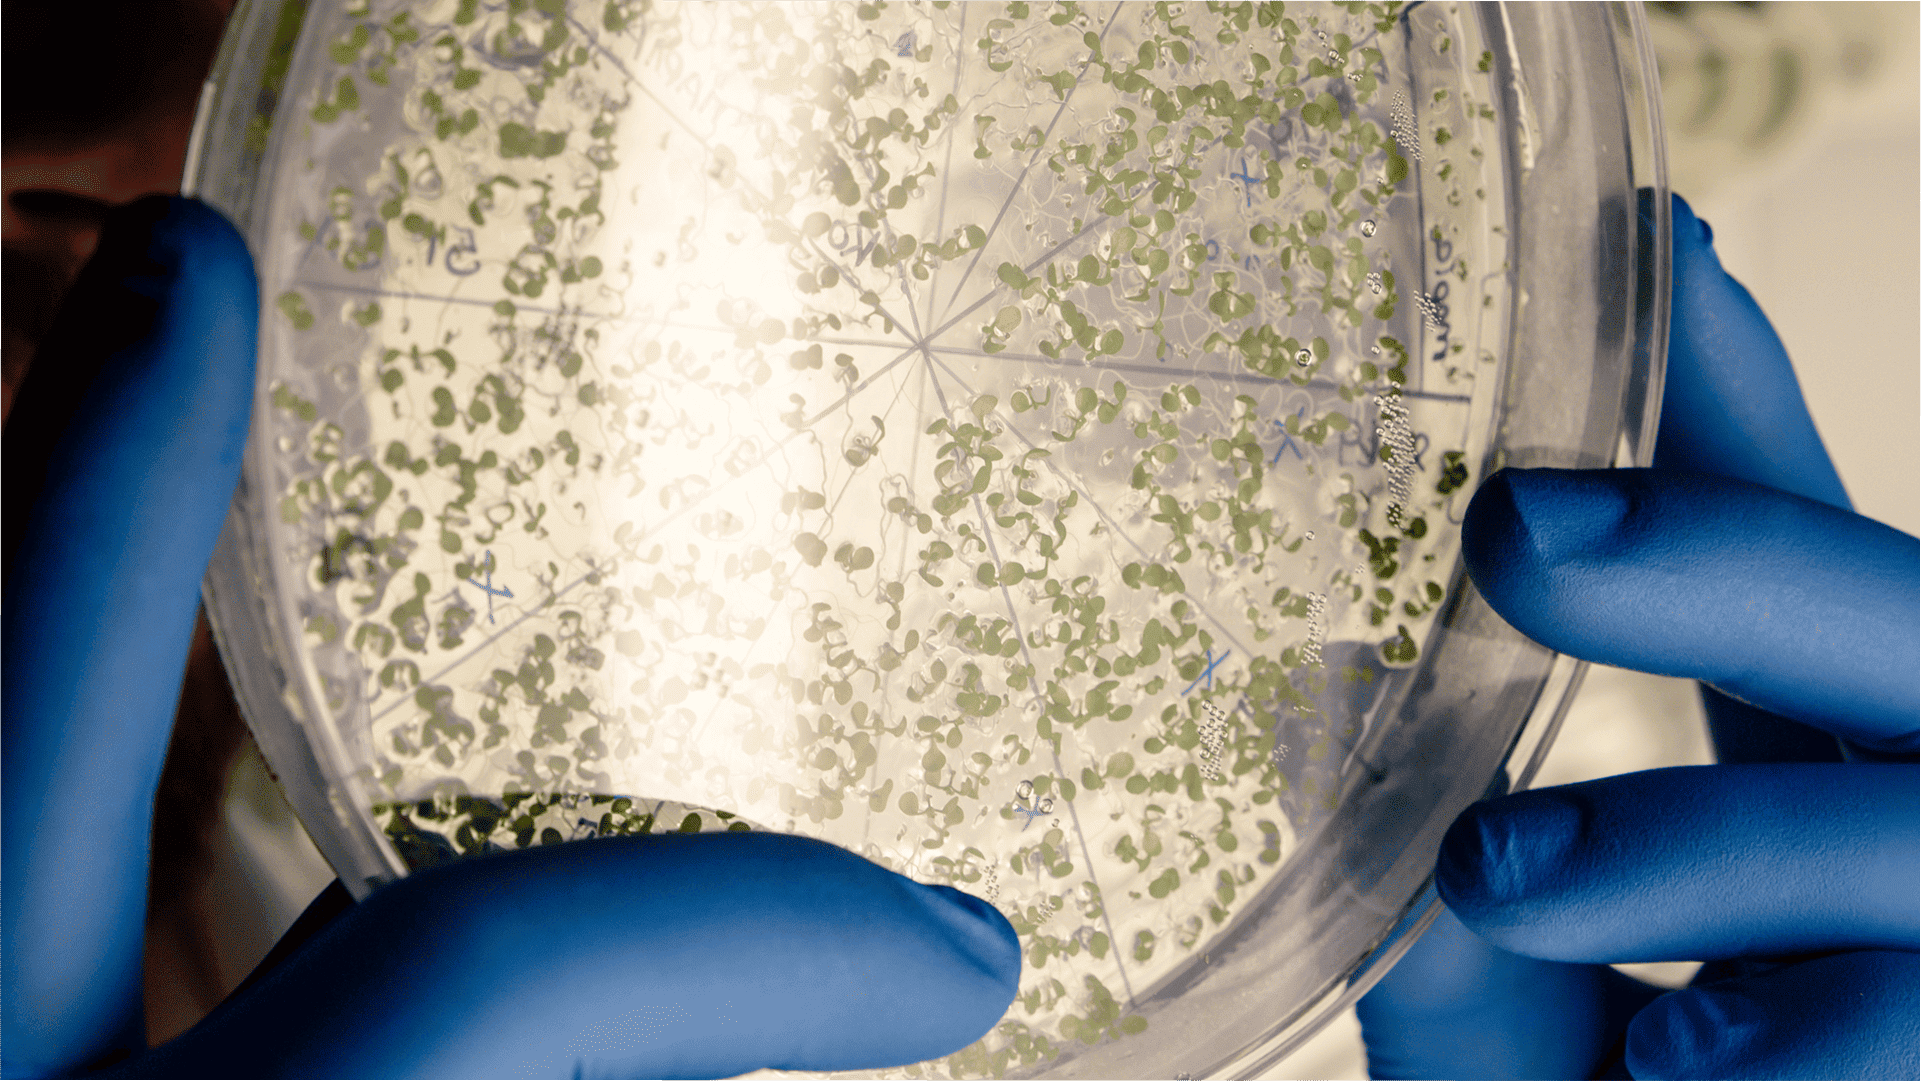
bactérias

O teste de microbiota intestinal é um exame que analisa as bactérias que vivem no nosso intestino, algo que hoje a ciência já sabe que influencia na digestão e na absorção dos nutrientes, na imunidade, no metabolismo, no humor e na saciedade.
De forma simples, ele mostra micro-organismos em excesso, micro-organismos que estão faltando e como esse ecossistema está funcionando. Não é um exame de fezes comum, mas uma análise genética avançada que identifica o DNA das bactérias. Vale a pena fazê-lo principalmente para quem tem sintomas persistentes, como constipação, diarreia, gases, distensão abdominal, refluxo, intolerâncias alimentares ou doenças metabólicas.
O objetivo não é dar um diagnóstico isolado, mas orientar um tratamento intestinal mais personalizado e eficiente. Ele ajuda o profissional, seja médico ou nutricionista, a escolher a melhor dieta, suplementos, probióticos e prebióticos, além de ajustes no estilo de vida. É como analisar o solo antes de plantar para saber o que precisa ser corrigido.
Esses testes são feitos em laboratórios especializados a partir de uma amostra de fezes coletada em casa. Cuidar do intestino não é modinha.